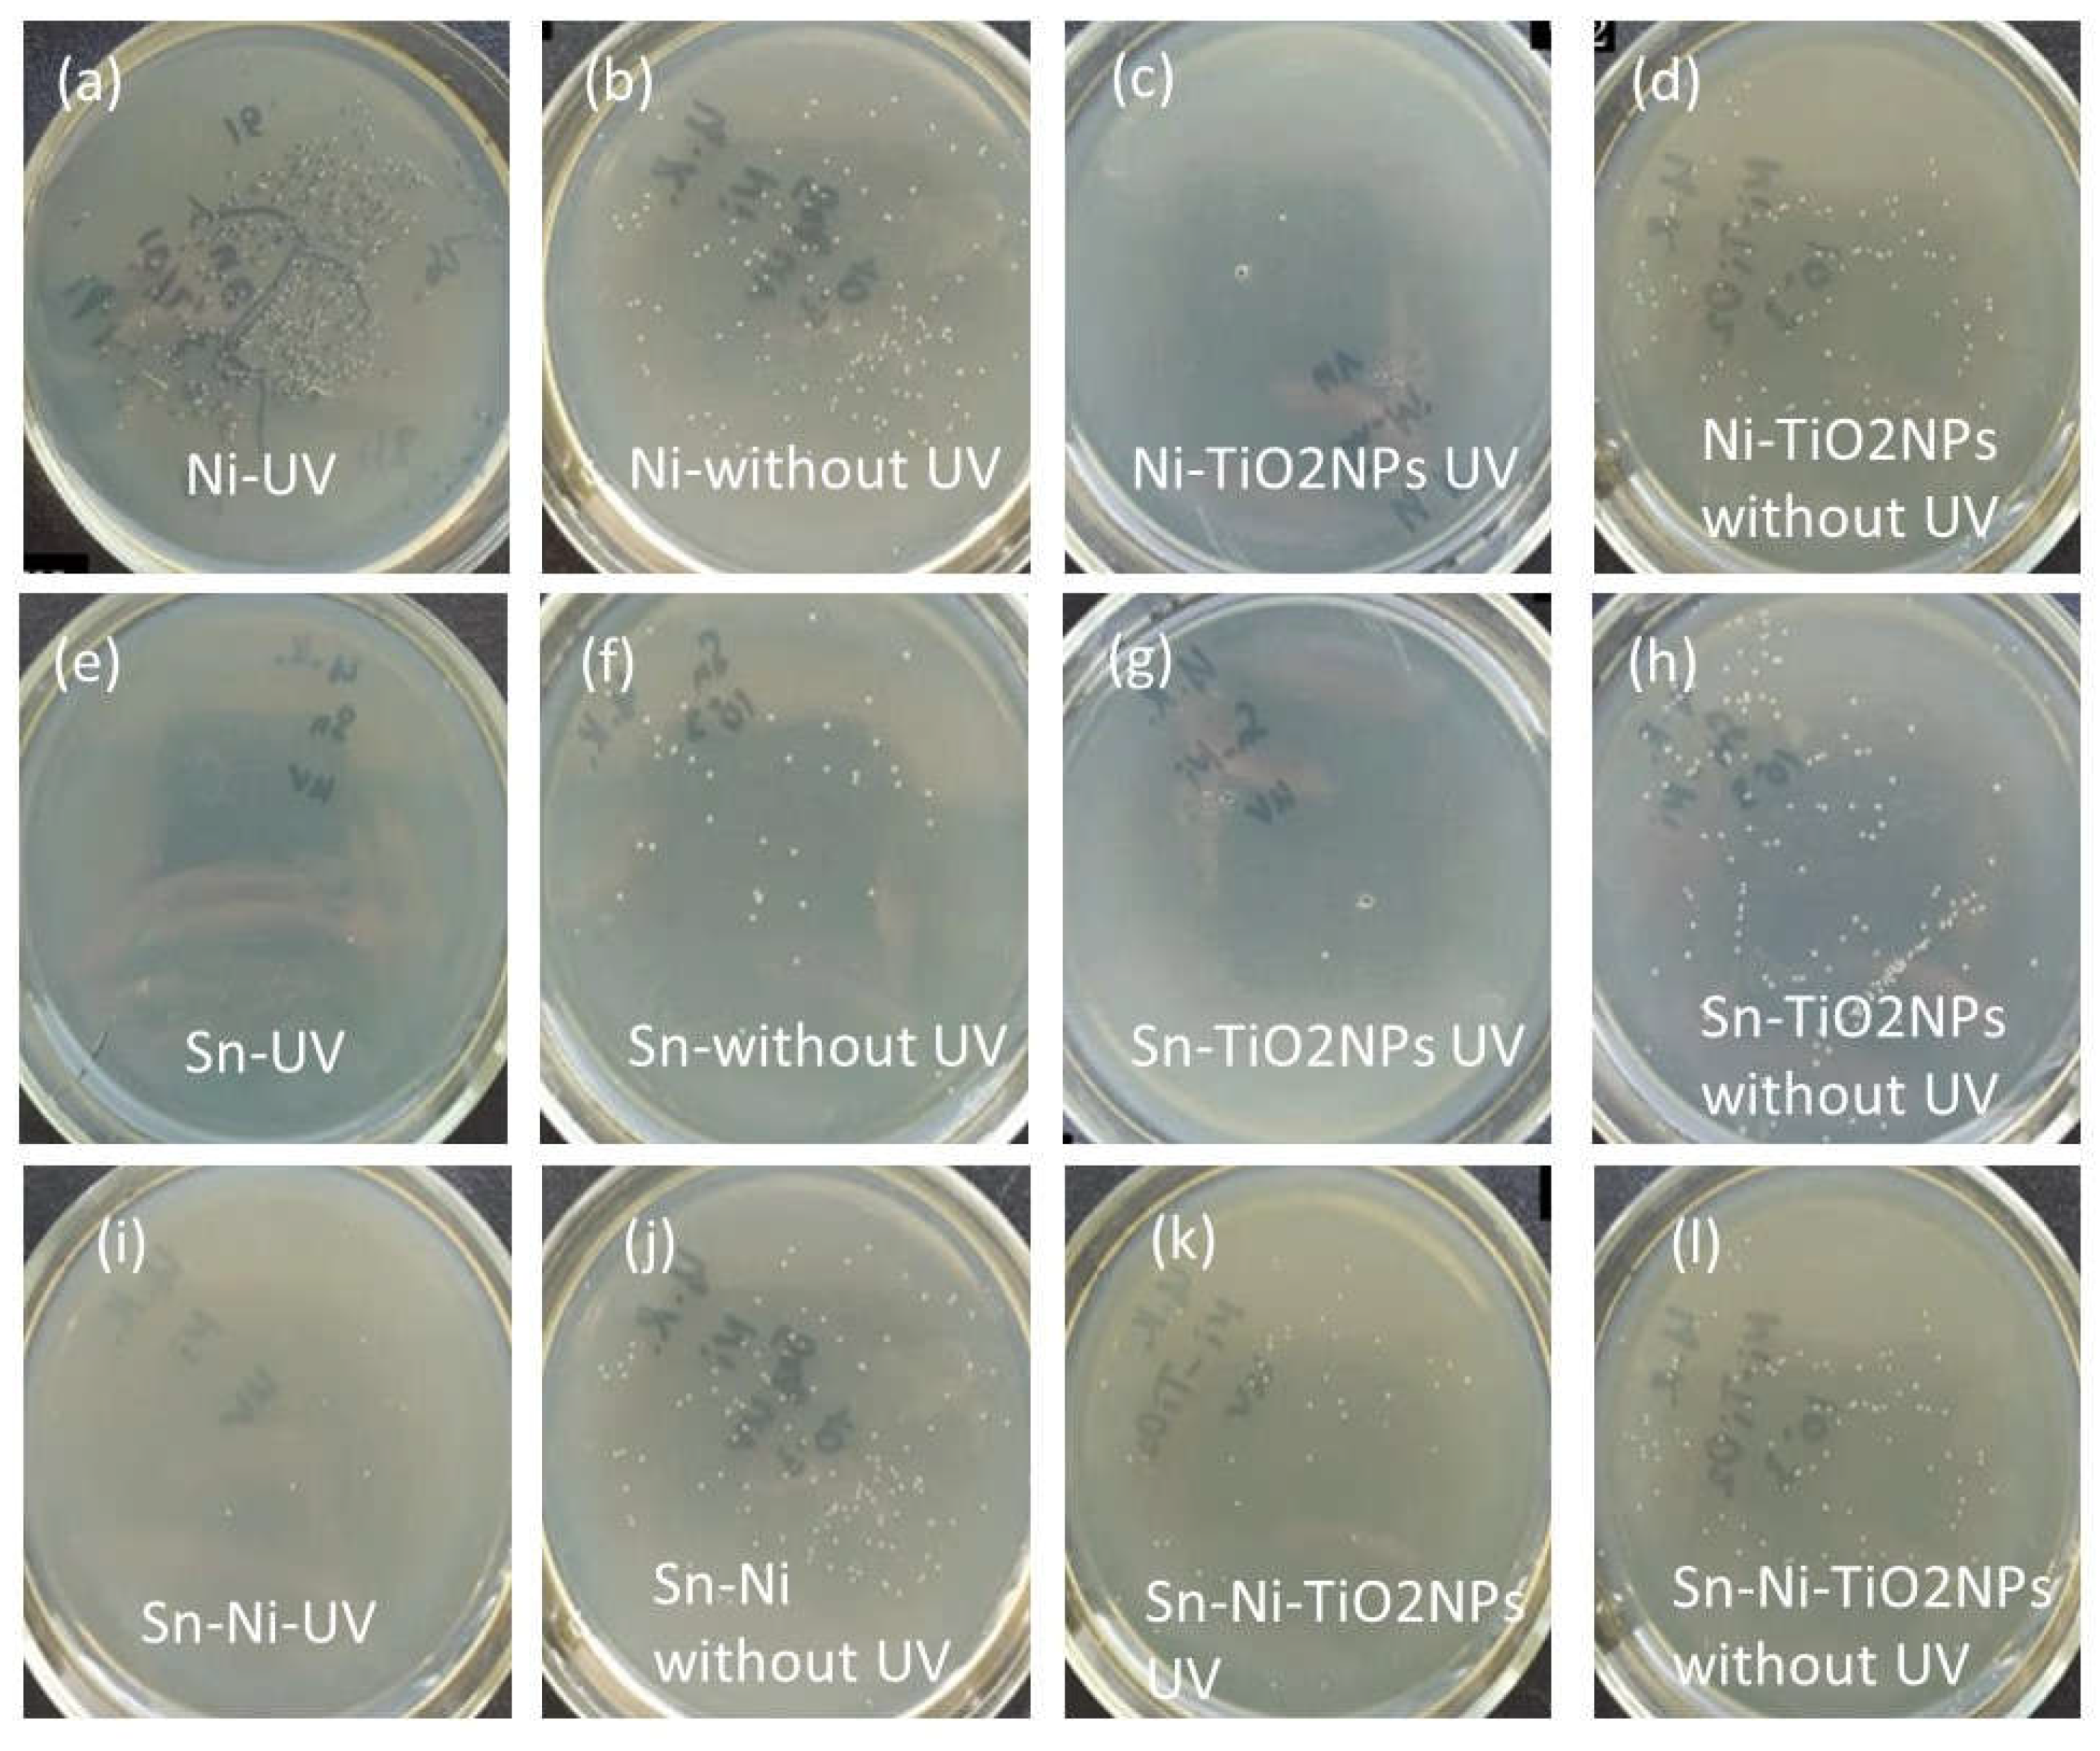

Submitted:
03 September 2024
Posted:
04 September 2024
You are already at the latest version
Abstract
Keywords:
1. Introduction
2. Materials and Methods


3. Results
Influence of Current Density on Cathode Current Efficiency
The Influence of TiO2NPs Concertation on Structure and Composition of Deposited Coating Based on Sn-Ni Alloy



Corrosion Properties






4. Conclusions
Author Contributions
Funding
Institutional Review Board Statement
Informed Consent Statement
Data Availability Statement
Acknowledgments
Conflicts of Interest
References
- Pop, A.B.; Iepure, G.; Titu, A.M.; Ravai-Nagy, S. Characterization and corrosion behavior of zinc coatings for two anti-corrosive protections: a detailed study. Coatings. 2023, 13, 1460. [Google Scholar] [CrossRef]
- Klapper, H. S.; Zadorozne, N. S.; Rebak, R. B. Localized corrosion characteristics of nickel alloys: a review. Acta Metall. Sin. (Engl. Lett.) 2017, 30, 296–305. [Google Scholar] [CrossRef]
- Shi, T.; Liang, J.; Li, X.; Zhang, C.; Yang, H. Improving the corrosion resistance of aluminum alloy by creating a superhydrophobic surface structure through a two-step process of etching followed by polymer modification. Polymers 2022, 14, 4509. [Google Scholar] [CrossRef]
- Prando, D.; Brenna, A.; Diamanti, M.V. Corrosion of titanium: part 1: aggressive environments and main forms of degradation. JABFM 2017, 15, e291–e302. [Google Scholar] [CrossRef]
- Zhang, D.; Wei, B.; Wu, Z.; Wang, Z. A comparative study on the corrosion behaviour of Al, Ti, Zr and Hf metallic coatings deposited on AZ91D magnesium alloys. Surf. Coat. Tech. 2016, 303, 94–102. [Google Scholar] [CrossRef]
- Shukla, P.; Awasthi, S.; Ramkumar, J.; Balani, K. Protective trivalent Cr-based electrochemical coatings for gun barrels. J. Alloys Compd. 2018, 768, 1039–1048. [Google Scholar] [CrossRef]
- Marchewka, J.; Kołodziejczyk, E.; Bezkosty, P. Characterization of electrochemical deposition of copper and copper(I) oxide on the carbon nanotubes coated stainless steel substrates. Sci. Rep. 2023, 13, 6786. [Google Scholar] [CrossRef]
- Chen, M.; Liu, D.; Zi, B.; Chen, Y.; Liu, D.; Du, X.; Pan, H. Remarkable synergistic effect in cobalt-iron nitride/alloy nanosheets for robust electrochemical water splitting. J. Energy Chem. 2022, 65, 405–414. [Google Scholar] [CrossRef]
- Wei, B.; Legut, D.; Sun, S.; Wang, H. T.; Shi, Z. Z.; Zhang, H. J.; Zhang, R. F. Synergistic effect of solute and strain on the electrochemical degradation in representative Zn-based and Mg-based alloys. Corros. Sci. 2021, 188, 109539. [Google Scholar] [CrossRef]
- Marinou, A.; Lekatou, A.G.; Xanthopoulou, G.; Vekinis, G. Electrochemical behavior of nickel aluminide coatings produced by CAFSY method in aqueous NaCl solution. Coatings 2022, 12, 1935. [Google Scholar] [CrossRef]
- Wu, P.; Xue, Z.; Yu, T.; Penkov, O.V. Transparent self-cleaning coatings: a review. Coatings 2023, 13, 1270. [Google Scholar] [CrossRef]
- Wang, S.; Wan, Y.; Song, N. Automatically generated datasets: present and potential self-cleaning coating materials. Sci. Data 2024, 11, 146. [Google Scholar] [CrossRef] [PubMed]
- Zheng, S.; Li, C.; Zhang, Y.; Xiang, T.; Cao, Y.; Li, Q.; Chen, Z. A General strategy towards superhydrophobic self-cleaning and anti-corrosion metallic surfaces: an example with aluminum alloy. Coatings 2021, 11, 788. [Google Scholar] [CrossRef]
- Su, F.; Yao, K. Facile Fabrication of superhydrophobic surface with excellent mechanical abrasion and corrosion resistance on copper substrate by a novel method. ACS Appl. Mater. Interfaces 2014, 6, 8762–8770. [Google Scholar] [CrossRef] [PubMed]
- Kharitonov, D. S.; Kasach, A. A.; Sergievich, D. S.; Wrzesińska, A.; Bobowska, I.; Darowicki, K.; Kurilo, I. I. Ultrasonic-assisted electrodeposition of Cu-Sn-TiO2 nanocomposite coatings with enhanced antibacterial activity. Ultrason. Sonochem. 2021, 75, 105593. [Google Scholar] [CrossRef]
- Kasach, A. A.; Kharytonau, D. S.; Zharskii, I. M.; Kurilo, I. I. Electrocrystallisation of Cu-Sn-TiO2 composite coatings in sulphuric acid electrolytes. Condens. Matter and Interphases. 2022, 24, 220–226. [Google Scholar] [CrossRef]
- Mitra, D.; Kang, E.-T.; Neoh, K. G. Antimicrobial copper-based materials and coatings: potential multifaceted biomedical applications. ACS Appl. Mater. Interfaces 2020, 12, 21159–21182. [Google Scholar] [CrossRef]
- Bharadishettar, N.; Bhat, K.U.; Bhat Panemangalore, D. Coating technologies for copper based antimicrobial active surfaces: a perspective review. Metals 2021, 11, 711. [Google Scholar] [CrossRef]
- O'Regan, B.C.; Grätzel, M. A low-cost, high-efficiency solar cell based on dye-sensitized colloidal TiO2 films. Nature 1991, 353, 737–740. [Google Scholar] [CrossRef]
- Murashkevich, A.N.; Alisienok, O.A.; and Zharskii, I.M. Physicochemical and photocatalytic properties of nanosized titanium dioxide deposited on silicon dioxide microspheres, Kinet. Catal. 2011, 52, 830. [Google Scholar]
- Jain, A.; Vaya, D. Photocatalytic activity of TiO2 nanomaterial. J. Chil. Chem. Soc. 2017, 62, 3683–3690. [Google Scholar] [CrossRef]
- Mhadhbi, M.; Abderrazak, H.; Avar, B. Synthesis and Properties of Titanium Dioxide Nanoparticles. 2023. [Google Scholar] [CrossRef]
- Freyre-Fonseca, V.; Téllez-Medina, D. I.; Medina-Reyes, E. I.; Cornejo-Mazón, M.; López-Villegas, E. O.; Alamilla-Beltrán, L.; Gutiérrez-López, G. F. Morphological and physicochemical characterization of agglomerates of titanium dioxide nanoparticles in cell culture media. J. Nanomater. 2016, 1–19. [Google Scholar] [CrossRef]
- Arumugam, C.; Velu, N.; Radhakrishnan, P.; Roy, V.A.L.; Anantha-Iyengar, G.; Lee, D.-E.; Kannan, V. Studies on the functional properties of titanium dioxide nanoparticles distributed in silyl–alkyl bridged polyaniline-based nanofluids. Nanomaterials 2023, 13, 2332. [Google Scholar] [CrossRef] [PubMed]
- Mehraz, S.; Luo, W.; Swiatowska, J.; Bezzazi, B.; Taleb, A. Hydrothermal synthesis of TiO2 aggregates and their application as negative electrodes for lithium–ion batteries: the conflicting effects of specific surface and pore size. Materials 2021, 14, 916. [Google Scholar] [CrossRef] [PubMed]
- Praveen, B. M.; Venkatesha, T. V.; Naik, Y. A.; Prashantha, K. Corrosion behavior of Zn-TiO2 composite coatings. Synth. React. Inorg. Met. Nano-Met. Chem. 2007, 37, 461–465. [Google Scholar] [CrossRef]
- Kang, B.; Lan, D.; Liu, L.; Dang, R.; Yao, C.; Liu, P.; Ma, F.; Qi, S.; Chen, X. Antibacterial activity and bioactivity of Zn-Doped TiO2 coating for implants. Coatings 2022, 12, 1264. [Google Scholar] [CrossRef]
- Makarava, I.; Esmaeili, M.; Kharytonau, D.S.; Pelcastre, L.; Ryl, J.; Bilesan, M.R.; Vuorinen, E.; Repo, E. Influence of CeO2 and TiO2 particles on physicochemical properties of composite nickel coatings electrodeposited at ambient temperature. Materials 2022, 15, 5550. [Google Scholar] [CrossRef]
- Baghery, P.; Farzam, M.; Mousavi, A. B.; Hosseini, M. Ni–TiO2 nanocomposite coating with high resistance to corrosion and wear. Surf. Coat. Technol. 2010, 204, 3804–3810. [Google Scholar] [CrossRef]
- Thiemig, D.; Bund, A. Characterization of electrodeposited Ni–TiO2 nanocomposite coatings. Surf. Coat. Technol. 2008, 202, 2976–2984. [Google Scholar] [CrossRef]
- Mozhgan, S.; Mahdi, M.; Seyed, M.E.; Mohammad, A. The role of TiO2 nanoparticles on the topography and hydrophobicity of electrodeposited Ni–TiO2 composite coating, Surf. Topogr.: Metrol. Prop. 2020, 8, 025008. [Google Scholar] [CrossRef]
- Birlik, I.; Ak Azem, N.F.; Toparli, M.; Celik, E.; Koc Delice, T.; Yildirim, S.; Bardakcioglu, O.; Dikici, T. Preparation and characterization of Ni–TiO2 nanocomposite coatings produced by electrodeposition Technique. Front. Mater. 2016, 3, 46. [Google Scholar] [CrossRef]
- Rosolymou, E.; Karantonis, A.; Pavlatou, E.A. Effects of direct and pulse plating on the co-deposition of Sn–Ni/TiO2 composite coatings. Materials 2024, 17, 392. [Google Scholar] [CrossRef]
- Rosolymou, E.; Spanou, S.; Zanella, C.; Tsoukleris, D.S.; Kohler, S.; Leisner, P.; Pavlatou, E.A. Electrodeposition of photocatalytic Sn–Ni matrix composite coatings embedded with doped TiO2 particles. Coatings 2020, 10, 775. [Google Scholar] [CrossRef]
- Pyanko, A.V.; Makarova, I.V.; Kharitonov, D.S.; Makeeva, I.S.; Sergievich, D.S.; Chernik, A.A. Physicochemical and Biocidal Properties of Nickel–Tin and Nickel–Tin—Titania Coatings. Prot. Met. Phys. Chem. Surf. 2021, 57, 88–95. [Google Scholar] [CrossRef]
- Pyanko, A.V.; Makarova, I.V.; Kharitonov, D.S.; Makeeva, I.S.; Alisienok, O.A.; Chernik, A.A. Tin–Nickel–Titania Composite Coatings. Inorg. Mater. 2019, 55, 568–575. [Google Scholar] [CrossRef]
- Qader, I. Studying the Effect of TiO2 Coating and Improving Biocompatibility of NiTiSn Biomedical Shape Memory Alloys. Thesis for: Ph.D. 2021. [Google Scholar] [CrossRef]
- Wan, C.; Zhang, L.; Liu, X. Corrosion assessment of Sn–Ni alloy coatings using neutral salt spray tests and electrochemical methods. Int. J. Electrochem. Sci. 2020, 15, 26–38. [Google Scholar] [CrossRef]
- Wan, C.; Liu, X.; Ye, J. Tailorable deposition of Sn–Ni alloy from a pyrophosphate bath with an adjustable Sn:Ni molar ratio. Surf. Coatings Technol. 2019, 369, 244–251. [Google Scholar] [CrossRef]
- Subramanian, B.; Mohan, S.; Jayakrishnan, S. Selective area deposition of tin-nickel alloy-an alternative for decorative chromium plating. J. Appl. Electrochem. 2007, 37, 219–224. [Google Scholar] [CrossRef]
- Laˇcnjevac, U.; Jovi´c, B.M.; Jovi´c, V.D. Electrodeposition of Ni, Sn and Ni–Sn alloy coatings from pyrophosphate-glycine bath. J. Electrochem. Soc. 2012, 159. [Google Scholar] [CrossRef]
- Rudnik, E. The influence of sulfate ions on the electrodeposition of Ni-Sn alloys from acidic chloride-gluconate baths. J. Electroanal. Chem. 2014, 726, 97–106. [Google Scholar] [CrossRef]
- Jalota, S.K. Tin–nickel alloy plating. Met. Finish. 1999, 97, 319–322. [Google Scholar] [CrossRef]
- Kuznetsov, B.V.; Vorobyova, T.N.; Glibin, V.P. A Comparative study of tin-nickel alloys obtained by electroplating and casting. Met. Finish. 2013, 111, 38–42. [Google Scholar] [CrossRef]
- Lowenheim, F.A.; Sellers, W.W.; Carlin, F.X. The protective value of tin-nickel alloy deposits on steel. J. Electrochem. Soc. 1958, 105, 338–346. [Google Scholar] [CrossRef]
- Shetty, S.; Hegde, A.C. Electrodeposition of Sn-Ni alloy coatings for water-splitting application from alkaline medium. Metall. Mater. Trans. B. 2017, 48, 632–641. [Google Scholar] [CrossRef]
- Refaey, S.A.M.; Taha, F.; Hasanin, T.H.A. Electrochemical behavior of Sn-Ni nanostructured compound in alkaline media and the effect of halide ions. Appl. Surf. Sci. 2004, 227, 416–428. [Google Scholar] [CrossRef]
- Zhu, Y.; Liu, T.; Li, L.; Song, S.; Ding, R. Nickel-based electrodes as catalysts for hydrogen evolution reaction in alkaline media. Ionics 2018, 24, 1121–1127. [Google Scholar] [CrossRef]
- Laˇcnjevac, U.C.; Jovi´c, V.D.; Jovi´c, B.M. Electrodeposition and characterization of Ni–Sn alloy coatings as cathodematerial for hydrogen evolution reaction in alkaline solutions. ZAŠTITA Mater. 2011, 52, 153–158. [Google Scholar]
- Benea, L.; Danaila, E. Nucleation and growth mechanism of Ni/TiO2 nanoparticles electro-codeposition. J. Electrochem. Soc. 2016, 163, D655–D662. [Google Scholar] [CrossRef]
- Xue, Y.; Wang, S.; Zhao, G.; Taleb, A.; Jin, Y. Fabrication of NiCo coating by electrochemical deposition with high super-hydrophobic properties for corrosion protection. Surf. Coat. Technol. 2019, 363, 352–361. [Google Scholar] [CrossRef]
- Liang, C.; Liu, X.; Teng, F.; Li, Y.; Gao, Sh. TiO2/EP superhydrophobic composite coating with excellent mechanical and chemical stability. Surf. Coat. Technol. 2024, 481, 130641. [Google Scholar] [CrossRef]
- Basavegowda, N.; Baek, K.-H. Multimetallic nanoparticles as alternative antimicrobial agents: challenges and perspectives. Molecules 2021, 26, 912. [Google Scholar] [CrossRef] [PubMed]
- Gold, K.; Slay, B.; Knackstedt, M.; Gaharwar, A. K. Antimicrobial activity of metal and metal-oxide based nanoparticles. Adv. Therap. 2018, 1, 1700033. [Google Scholar] [CrossRef]
- Celardo, I.; Pedersen, J. Z.; Traversa, E.; Ghibelli, L. Pharmacological potential of cerium oxide nanoparticles. Nanoscale 2011, 3, 1411. [Google Scholar] [CrossRef] [PubMed]
- Arreche, R.; Bellotti, N.; Blanco, M.; Vázquez, P. Synthesis and characterization of zirconium oxides for use as antimicrobial additives in paints. Proc. Mat. Sc. 2015, 9, 627–634. [Google Scholar] [CrossRef]
- Nguyen, N.T.; Grelling, N.; Wetteland, C.L.; Rosario, R.; Liu, H. Antimicrobial activities and mechanisms of magnesium oxide nanoparticles (nMgO) against pathogenic bacteria, yeasts, and biofilms. Sci. Rep. 2018, 8, 16260. [Google Scholar] [CrossRef]
- Liu, K.; Cheng, F.; Luo, Y.; Liu, L.; Wang, C.; Xie, K.; Luo, X. Porous single crystalline-like titanium dioxide monolith with enhanced photoelectrochemical performance. Front. Mater 2023, 10, 1177093. [Google Scholar] [CrossRef]
- Alshibeh, A. N.; Vacandio, F.; Vassalo, L.; Djenizian, T.; Coulomb, B.; Boudenne, J.-L. Effects of mode of preparation of titanium dioxide nanotube arrays on their photocatalytic properties: application to p-nitroaniline degradation. Micro 2023, 3, 369–381. [Google Scholar] [CrossRef]
- Lowry, G.V.; Gregory, K.B.; Apte, S.C.; Lead, J.R. Transformations of nanomaterials in the environment. Environ. Sci. Technol. 2012, 46, 6893–6899. [Google Scholar] [CrossRef]
- Oktar, F.N.; Yetmez, M.; Ficai, D.; Ficai, A.; Dumitru, F.; Pica, A. Molecular mechanism and targets of the antimicrobial activity of metal nanoparticles. Curr. Top. Med. Chem. 2015, 15, 1583–1588. [Google Scholar] [CrossRef]
- Ibáñez, J. A.; Litter, M. I.; Pizarro, R. A. Photocatalytic bactericidal effect of TiO2 on Enterobacter cloacae. J. Photochem. Photobiol. A 2003, 157, 81–85. [Google Scholar] [CrossRef]
- Wyszogrodzka, G.; Marszalek, B.; Gil, B.; Dorozynski, P. Metal-organic frameworks: mechanisms of antibacterial action and potential applications. Drug Discovery Today 2016. [Google Scholar] [CrossRef] [PubMed]
- Abdal Dayem, A.; Hossain, M.; Lee, S.; Kim, K.; Saha, S.; Yang, G.-M.; Cho, S.-G. The role of reactive oxygen species (ROS) in the biological activities of metallic nanoparticles. Int. J. Mol. Sci. 2017, 18, 120. [Google Scholar] [CrossRef] [PubMed]
- Sandulescu, A.; Anastasescu, C.; Papa, F.; Raciulete, M.; Vasile, A.; Spataru, T.; Scarisoreanu, M.; Fleaca, C.; Mihailescu, C.N.; Teodorescu, V.; et al. Advancements on basic working principles of photo-driven oxidative degradation of organic substrates over pristine and noble metal-modified TiO2. Model case of phenol photo oxidation. Catalysts 2021, 11, 487. [Google Scholar] [CrossRef]
- Laxma Reddy, P. V.; Kavitha, B.; Kumar Reddy, P. A.; Kim, K.-H. TiO2-based photocatalytic disinfection of microbes in aqueous media: A review. Environ. Res. 2017, 154, 296–303. [Google Scholar] [CrossRef]
- Anandgaonker, P.; Kulkarni, G.; Gaikwad, S.; Rajbhoj, A. Synthesis of TiO2 nanoparticles by electrochemical method and their antibacterial application. Arab. J. Chem. 2015. [Google Scholar] [CrossRef]
- Younis, A.B.; Milosavljevic, V.; Fialova, T.; Smerkova, K.; Michalkova, H.; Svec, P.; Antal, P.; Kopel, P.; Adam, V.; Zurek, L.; Dolezelikova, K. Synthesis and characterization of TiO2 nanoparticles combined with geraniol and their synergistic antibacterial activity. BMC Microbiol. 2023, 23, 207. [Google Scholar] [CrossRef]
- Du, T.; Huang, B.; Cao, J.; Li, C.; Jiao, J.; Xiao, Z.; Wei, L.; Ma, J.; Du, X.; Wang, Sh. Ni nanocrystals supported on graphene oxide: antibacterial agents for synergistic treatment of bacterial infections. ACS Omega 2022, 7, 18339–18349. [Google Scholar] [CrossRef]
- Yasuyuki, M.; Kunihiro, K.; Kurissery, S.; Kanavillil, N.; Sato, Y.; Kikuchi, Y. Antibacterial properties of nine pure metals: a laboratory study using Staphylococcus aureus and Escherichia coli. Biofouling 2010, 26, 851–858. [Google Scholar] [CrossRef]

Disclaimer/Publisher’s Note: The statements, opinions and data contained in all publications are solely those of the individual author(s) and contributor(s) and not of MDPI and/or the editor(s). MDPI and/or the editor(s) disclaim responsibility for any injury to people or property resulting from any ideas, methods, instructions or products referred to in the content. |
© 2024 by the authors. Licensee MDPI, Basel, Switzerland. This article is an open access article distributed under the terms and conditions of the Creative Commons Attribution (CC BY) license (http://creativecommons.org/licenses/by/4.0/).
